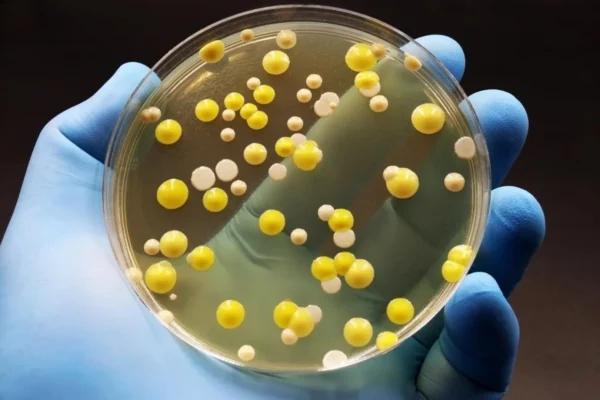

Graphene kills harmful bacteria “superbugs” but spares human cells
Hygiene is essential for everyday items that come into close contact with the body, including clothing, masks, and toothbrushes. Scientists have now uncovered how graphene can selectively eliminate bacteria while leaving human cells unharmed. This discovery points to a new class of antibacterial materials that could be both safe for people and capable of reducing…








